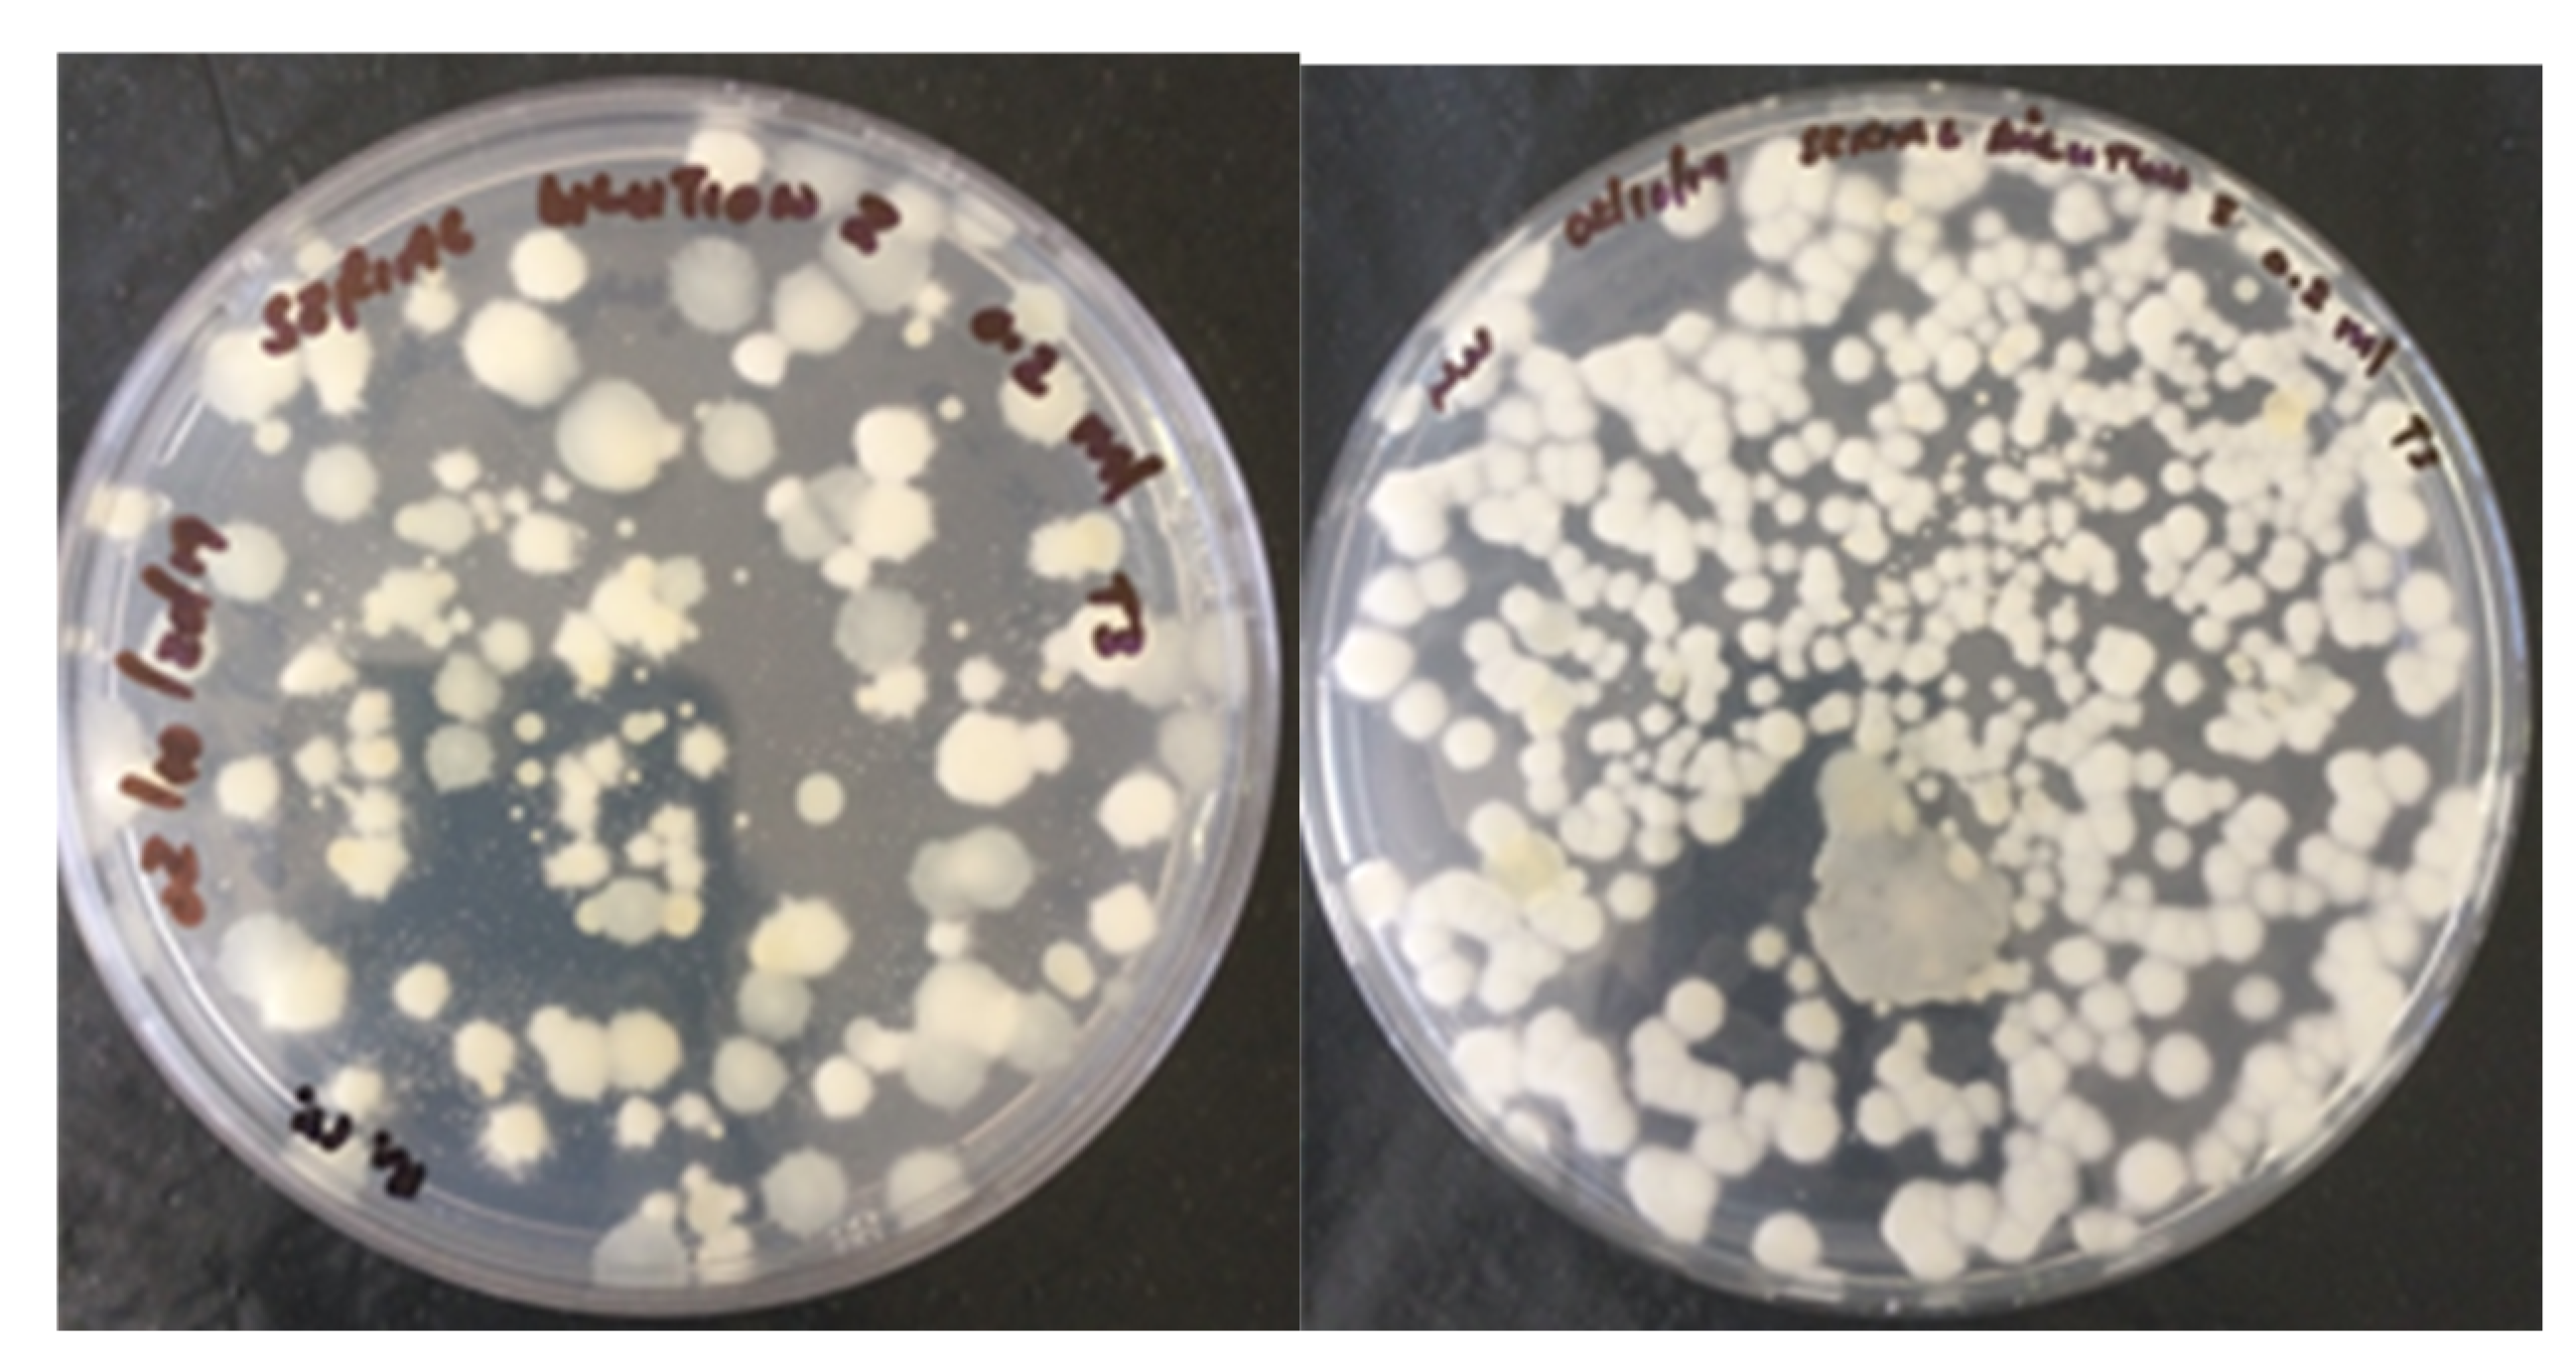
Microorganisms 09 01184 g001
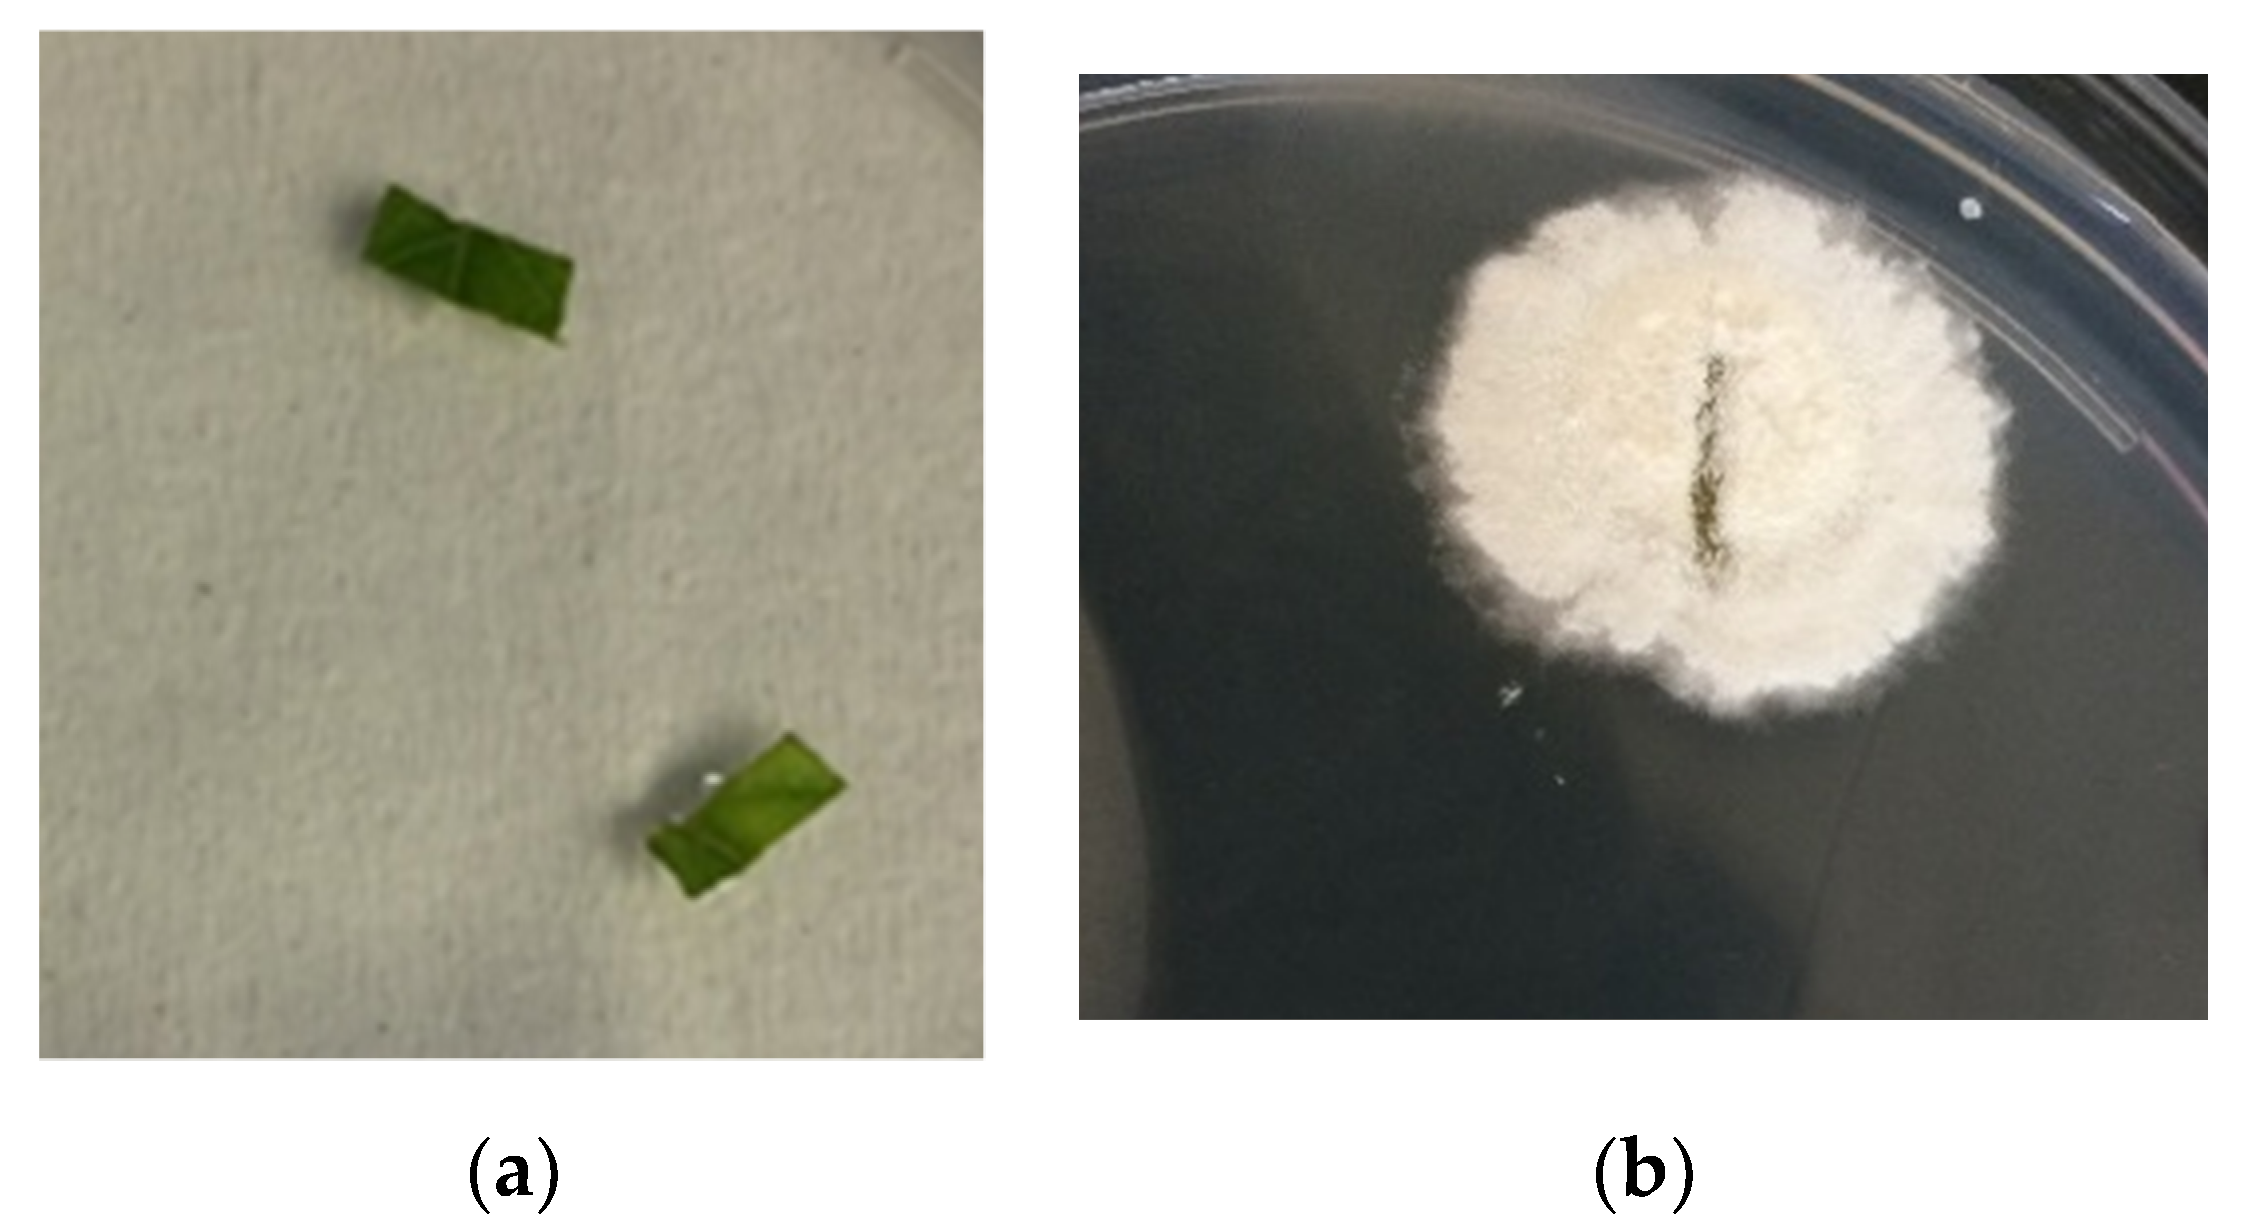
Microorganisms 09 01184 g002

1. Introduction
Numerous drawbacks, including farming practices, transportation, storage of perishable food crops, inefficient disposal, and pollution [
1], are associated with the poor management of organic wastes. It is, therefore, not surprising that it has led to an increased exploration into alternative solutions to the management and beneficiation of organic wastes. Compost is an eco-friendly natural material obtained when organic plant residues are reduced to organic fertilizer and soil conditioners through a biological process known as composting [
2,
3]. Since fungi and bacteria are integral components of composting, it is possible to optimize the quality, biophysicochemical constituents, and yield of the end-product of composting through manipulations of fungal content in composting materials.
Reports over the years on the potential enhancement effects of entomopathogenic microbes on composting processes, though few, have opened new opportunities for managing solid organic wastes through the use of fungal inocula. Fungal species are present during the mesophilic and thermophilic stages of composting [
4]. Dead organic materials serve as their host and provide energy to the fungi responsible for the breakdown of organic matter [
5,
6], and in the process, the fungal saprophytes enhance the biodegradation of the recalcitrant lignocellulose of plant-based organic matter [
7]. Hence, certain saprophytic fungi play a vital role in the decomposition and conversion process during composting [
5,
8,
9,
10]. Interestingly, entomopathogenic fungi have also been reported to produce lignocellulolytic enzymes, such as endoproteases, aminopeptidases, esterases, and chitinases [
11], all of which play crucial roles during composting [
12,
13]. It is therefore not surprising that entomopathogenic fungal species have been grouped among microorganisms that biodegrade or mineralize organic materials [
6].
A literature survey showed that there is very little information available on fungal inoculants and their ability to optimize the biodegradation of solid raw materials to humus. For example, four mesophilic fungi,
Aspergillus niger, Aspergillus sp. (R.),
Thrichoderma viride, and
Penicillium sp., that were inoculated into compost materials consisting of jowar (
Sorghum bicolor) stalk, wheat (
Triticum aestivum) straw (5:3), and jamun (
Syzygium cumini) leaves, reduced the composting duration by one month and improved the quality of the composted end-product [
14]. Three bacterial isolates have also been reported to improve the chemical characteristic of end-products obtained from composting [
15]. Inspiring findings, such as the aforementioned, have motivated researchers to further investigate the mechanisms through which saprophytic fungi influence the decomposition of raw organic wastes, as well as the quality of the end-products of composting. Evidently, this knowledge will improve our understanding and utilization of the fungus–plant residue relationship for sustainable waste management. Some fungal entomopathogens have been reported to enhance plant growth and plant resistance to phytopathogens and herbivores [
16]. Moreover, these fungi can persist in soils and growth media, while offering protection to plants and improving plant nutrition [
17,
18]. They also produce hormones, signaling factors [
19], and nutrients [
20] that can enhance plant growth.
Solid organic vegetable waste and spoilage is a serious challenge faced by many developing countries [
15]. These types of residues are recalcitrant and difficult to decompose. The addition of conidia of entomopathogenic fungal endophytes to raw composting materials could potentially enhance the composting process, resulting in improved biophysicochemical characteristics, such as a high nutrient content and compost maturity. These fungi can also contribute to the production of high quality compost materials that can improve plant growth and health, and protect plants against arthropod pests; thus, contributing to the sustainable management and utilization of organic wastes. One well-known entomopathogenic fungal endophyte is
Clonostachys rosea, a soil-borne saprophyte that belongs to the phylum Ascomycota and order Hypocreales.
Clonostachys rosea has some interesting traits that can affect the biophysicochemical properties of composts, as well as the composting of organic wastes. For example, the fungus can biotransform bioactive compounds, breakdown starch and plastics, and produce extracellular enzymes, secondary metabolites, and hydrocarbon [
21,
22].
Clonostachys rosea f.
catenula is a potentially ligninolytic fungus [
23] and a versatile antagonist against fungal pathogens of plants [
24]. The objective of this study was to evaluate the effect of
C. rosea f.
catenula inoculation on the biophysicochemical properties of compost, endophytic activity, phytotoxicity of composted materials, and the protective effect of the composted material containing the fungus against the insect infestation of potted tomatoes (
Solanum lycopersicum L.) by
Tetranychus urticae (Acari).
4. Discussion
The inoculation of
C. rosea f.
catenula on composting heaps did not show varied effects on the physical parameter of heap temperature over time in this study. The highest weekly average temperature recorded in this study was 39.35 °C, and this was relatively low when compared to similar studies [
34,
35]; however, the heaps in the current study were small and in open air conditions. Gaur et al. [
14] observed maximum temperatures of 45 °C and 51 °C during composting of a mixture of jowar stalk and wheat straw, and jamun leaves inoculated with
Aspergillus niger and
Trichoderma viride, respectively. However, the study by Sakar et al. [
36] differed from the present study. For example, the study by Sakar et al. [
36] did not show an increase in temperature in pits and earthen pots of compost wastes containing dung and market waste, and vegetable waste and dung, but when the ratio of 1:5 chopped rice straw was added to the waste, a heap temperature of 65.9 °C was observed after 24 h. The influence of the experimental conditions, such as heap size, ambient temperature and humidity, and turning frequencies on the composting process and the outcomes cannot be underestimated [
32]. Possible reasons for the low temperature of composting in the present study could have been due to the high water content of the solid vegetable wastes and frequent turning of the heaps in open air [
32]. Temperature is a key parameter in composting, as it indicates the state of decomposition and guarantees sanitation of the end-product [
37]. The rise and drop in temperature suggests that the composting process might have gone through three phases: the mesophilic, thermophilic, and maturation phases.
In this study, the data show that the effect of fungus on moisture content was not significant. However, the heap moisture content decreased in both treatments over time, from weeks 1 to 12. Moisture is considered as one of the important parameters affecting the composting process [
15,
38]. However, the moderate moisture content of 40–60% obtained in this study falls within the range of optimum moisture content for composting [
39]. Ribeiro et al. [
34] also expressed that values of 50 to 60% moisture content are ideal for efficient composting. Higher moisture content during composting causes waterlogging that might delay the composting process [
36,
40,
41,
42]. It is worth noting that the inoculation of composting materials with beneficial microorganisms has the potential to sustain the water content of heaps.
We also assessed the nutrient contents of the cabbage wastes in this study and found that N, P, K, Na, C, and B were not significantly influenced by exposing composting materials to a
C. rosea f.
catenula inoculum. These findings contradict those of Jusoh et al. [
43], who reported higher levels of P and K content (
p < 0.05) in a mixture of rice straw with a solution of effective microorganisms in comparison to those without microorganisms. This study recorded the same C/N ratio of 8:1 for both treatments in the end-product of composting (
Table 4). Nevertheless, Kumar et al. [
44] and Petric et al. [
45] reported results with essential C/N values between 20 and 50. Previously, Mtimkulu [
32] reported improved C/N ratio in treatments with spent wine filter material content (10:1; 13:1, and 10:1). A low C/N ratio suggests higher available nitrogen per carbon, and inert nitrogen [
46]. Yang et al. [
47], Wang et al. [
48], and Rastogi et al. [
49] observed decreased C/N ratios in the process of composting, which can be attributed to an elevated waste biodegradation (carbon) to mineralization (nitrogen) ratio.
Traditionally, C/N ratio is used to indicate the degree of maturity of compost [
50,
51]. Poincelot [
52] suggested that a C/N ratio below 20 is indicative of mature compost. Therefore, based on our results, fungal-treated compost heaps and control-treated heaps were mature and complete at the end of the composting period. Similarly, the N and C in the plant tissue nutrients did not show a significant difference (
p > 0.05) in both treatments; a higher C/N ratio (25:1) was obtained (
Table 7). Fungus treated heaps appeared to have a dark brown color compared to the control heaps. This effect demonstrates that perhaps the fungal inoculum enhanced the decomposition of organic wastes. This affirmation correlates with the findings of Sakar et al. [
36].
The existence of micronutrients, including some heavy metals, in the compost was determined at the end of the composting period, and interestingly, no effect on micro-nutrients was observed in the fungus-treated heaps compared with the control (
Table 4). Overall, these results suggest that inoculation of cabbage wastes with the
C. rosea f.
catenula strain did not change the chemical characteristics of the final product of composting. Previously, a decrease in the status of nutrients had been obtained by Chaturvedi et al. [
53], while, the findings of Jusoh et al. [
43] indicated that the composting process of rice straw containing effective microorganisms tended to increase heavy metals (Cu and Zn). Previous research by Paré et al. [
54] also explored the increased accumulation of heavy metals during the composting of biosolids. These trace metals are required in small quantities by plants, as they can be phytotoxic at high concentrations [
52]. Paré et al. [
54] confirmed that the extractability and exchangeability of some of these heavy metals could be reduced during the composting of biosolids and municipal solid wastes.
No differences in the pH values of the treated heaps and the control heaps over the period of composting were recorded. The pH in this study ranged from 4.5–7.0. Previous studies showed that pH values ranging from 5.5 to 9.0 are suitable for the composting process, while values between 6.5 to 8.0 are thought to be most effective [
55]. According to Chen et al. [
41], a pH range from 6.8 to 7.3 is optimum for composting. Zhang and Sun [
46] suggested that pH values from 5.5 to 8.0 are ideal for composting, whereas Bernal et al. [
39] suggested that a pH value from 6.7 to 9.0 is optimum to promote good microbial activities. The pH of compost has a noticeable effect on the microbial populace, and it increases as a result of the decomposition of acids, which releases ammonium [
15]. The pH values in the reports by Miller [
29], Christian et al. [
55], Sarkar et al. [
36], and Ribeiro et al. [
34] were closer to those observed in the present study (pH ranging between 7.0 and 7.6). This pH range of 7 to 7.6 is within the optimum range of 5.5 to 8.0 for compost pile materials with fungi [
41]; thereby, suggesting that the compost in the current study was subjected to good oxidation.
In this study,
C. rosea f.
catenula conidia were successfully re-isolated from the composted materials originating from fungus pre-treated heaps and from all tomato plants that were cultivated on the composted materials obtained from the fungus pre-treated heaps. These results suggest that the fungus was certainly persistent in the composted materials; thereby, enhancing endophytic quality of the composted materials.
C. rosea f.
catenula is potentially pathogenic to insects and antagonistic against phytopathogens. Hence, its presence should add value to organic composts. The re-isolation of
C. rosea f.
catenula from leaf sections of the cultivated tomato plants clearly demonstrated the
C. rosea f.
catenula strain used in this study was an efficient endophyte. The colonization of potted tomato plants by endophytic fungi has been reported previously [
56]. Xia et al. [
57] isolated six endophytic fungal isolates belonging to very diverse orders, such as Eurotiales, Pleosporales, Hypocreales, and Saccharomycetales. The recovery of
C. rosea f.
catenula from the leaves of the tomato plants, indicates the potential of these strains to become successful endophytic agents. Andrade-Linares et al. [
58] also reported endophytic colonization by species belonging to the genera
Verticillium,
Penicillium,
Cladosporium,
Fusarium, and
Trichoderma, which can also be isolated from stems. It is worth mentioning that successful colonization of fungal endophytes across different types of tissues is influenced by factors such as fungal species, fungal strain, and host [
59,
60,
61], as well as plant species, growth stages, soil types, and environmental conditions [
62]. Variability in the colonization efficiency of strawberry leaves [
63] and potato tubers [
64] with a different strain of
C. rosea was previously reported. Nordström [
65] reported variable colonization of tomato and
Arabidopsis thaliana by a
C. rosea f.
catenula strain. Sutton et al. [
20] also reported that
C. rosea is a plant endophyte on different plant species and was isolated from roots and stems of soya beans (
Glycine max), which were either inoculated with, or were grown in, soil infested with
C. rosea [
66]. Nordström [
65] suggested that the rhizosphere can affect the establishment of
C. rosea. In another study, it was reported that growth media has a greater influence on the level of plant endophytic colonization than the inoculation method [
67].
Clonostachys rosea f.
catenula was assessed against a tomato plant red spider mite infestation and the results showed that the fungus did not significantly reduce the insect infestation levels despite the high endophytism observed in this study, suggesting that many factors influence the efficacies of endophytic entomopathogens in vivo. Moloinyane and Nchu [
68] did not observe a reduction of grapevine mealy bug infestations by the endophyte
Beauveria bassiana, and they argued that factors such as host species, fungal strain, and insect species may influence the efficacy of endophytic entomopathogens on both the plant and the insect pest. However, inoculation method and the effect of endophytic colonization can be influenced by biotic and abiotic factors, such as growth substrate, plant species and age, fungal species and inoculum density [
59,
66,
69]. For instance, Tefera and Vidal [
59] demonstrated that despite the inoculation method used,
B. bassiana colonized the entire parts of sorghum plants. However, a study by Posada et al. [
69] showed that plants species, fungal isolate, and the inoculation methods used influenced the endophytic colonization by
B. bassiana. Some studies have demonstrated fungal endophytes reduces insect infestations [
16,
70,
71,
72,
73,
74]. For instance, the effect of environmental changes on colonization of corn by the fungal isolate
B. bassiana was reported by Bing and Lewis [
75] and its effect on targeted pests (European corn borer larvae)
Ostrinia nubilalis (Hübner). However, others did not find any benefit of endophytic fungal colonization on insect infestations [
68]. It appears many other factors moderated the fungus–plant–herbivore relationship, which research has shown is quite complex. It is worth noting that this fungus is known as an antagonist, and which is widely used as a biocontrol agent for divergent plant pathogens, including plant pathogenic fungi such as
Alternaria and
Fusarium species [
76].
Results of this study showed a superior germination of tomato seeds sown in composted materials from heaps that were inoculated with
C. rosea f.
catenula during composting, and no phytotoxicity was observed on percentage seedling growth in both treatments. The increased germination in treated compost, as well as the increased seedling growth, may have been due to the presence of the fungus. A recent study showed that endophytic fungi can produce phytohormones, particularly gibberellins, that alleviate the harmful effects of abiotic stresses and enhance crop growth [
77]. According to Davies [
78], these phytohormones can regulate various developmental and physiological processes in plants such as seed germination, seedling development, stem and leaf growth, and flower and fruit growth. Previous studies reported on plant-growth promoting fungi (PGPF) from various genera including,
Thrichoderma,
Fusarium, and
Penicillium, which can be beneficial in several crop plants [
79,
80]. A similar study has been reported, wherein
Penicillium oxalicum (
Pennisetum glaucum (L.) R. Br.) enhanced the seed germination and seedling vigor of Pearl millet [
81]. However, the authors indicated that the efficacy of the endophytic fungus may vary significantly among treatments. Similarly, [
79] observed enhanced seed germination and seedling vigor where seed priming with a conidial suspension of PGPF
T.
harzianum was used compared to a non-primed control in sunflower (
Helianthus annuus L.). Moreover, Jogaiah et al. [
82] demonstrated enhanced seed germination and seedling vigor in seeds of tomato treated with a conidial suspension of different PGPF. Murali et al. [
83] also demonstrated the use of these microbes as inoculants to treat seeds for germination and seedling growth. Herrera et al. [
84] found that seeds sown on a media composition of white peat mixed with municipal solid waste compost had better quality seedlings than those grown with standard peat mixtures. The compost:river sand ratio (25% treated compost and 75% course river sand) was a suitable treatment for the vegetative growth of seedlings in both treatments (
Table 5).
This study suggests that inoculating organic waste materials with endophytic entomopathogenic C. rosea f. catenula conidia could enhance the rate of decomposition of organic waste heaps, help to produce high quality composted materials rich in endophytes, and that composting materials could serve as a substrate for storing entomopathogenic fungi for long periods, and for fungal application in the field. The finished end-product from the fungus-inoculated heaps could improve the physical stability, chemical constituent richness, and promote plant vigor and growth enhancement. This compost end-product contains plant-growth promoting and protection properties and could substitute chemical fertilizers and synthetic pesticides, inhibit toxic chemicals to crop plants, and be recommendable in agricultural application. Future evaluation of enzymes could help to better understand the mechanism through which the fungus influences composting, changes in microbial species and populations over time, and identify the specific microbes involved. Assessment of phytotoxic chemicals of these fungi in composted materials could help understand the potential risk they may have in the cultivation of plants.